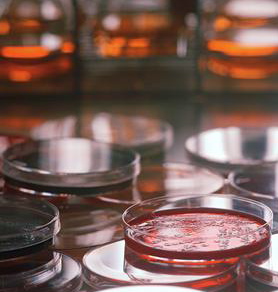

In the past two weeks I’ve presented blogs on various drug resistant bacteria. The first was about “Super Bugs” and another about “Deadly CRE”. These hardy bacteria are a growing concern worldwide since they have the ability to evolve to a point that traditional antibiotics are no longer ineffective against them.
about “Super Bugs” and another about “Deadly CRE”. These hardy bacteria are a growing concern worldwide since they have the ability to evolve to a point that traditional antibiotics are no longer ineffective against them.
The same type of drug-resistance, unfortunately, occurs with viruses. It happens with viruses that cause the common cold, flu viruses and other more deadly viruses.
The good news is that research scientists at the Washington University School of Medicine in St. Louis, Missouri have discovered a new, innovative approach to viral infections, even resistant ones—It’s Bee Venom!
in St. Louis, Missouri have discovered a new, innovative approach to viral infections, even resistant ones—It’s Bee Venom!
Scientists have found a key ingredient in bee venom that destroys HIV without harming surrounding cells. The bee venom compound is named mellitin, and researchers have loaded the toxin on nanoparticles structured with bumpers (think of cogs or gears on a wheel).
Normal cells bounce off of these nanoparticles because they’re too large to get caught  between the bumpers. The HIV virus, however, is small enough to fit between the bumpers and make contact with the surface of these nanoparticles. And that’s where the bee venom (mellitin) is placed.
between the bumpers. The HIV virus, however, is small enough to fit between the bumpers and make contact with the surface of these nanoparticles. And that’s where the bee venom (mellitin) is placed.
The mellitin fuses with the viral shell, called the viral envelope, and causes it to rupture; thus, it renders the virus inactive.
The difference between this technique and existing anti-HIV drugs is that those drugs don’t prevent the initial infection. Their mechanism of action is to inhibit the viruses’ ability to replicate. Eventually that mechanism becomes inactive because viruses are as smart as bacteria and evolve to evade the drug’s lethal action.
Mellitin is a much different approach in that this venom attacks the inherent structure of the virus. In effect, mellitin pokes holes in the protective envelope that surrounds HIV.
Although in the early stages of development, the implications for treatment are phenomenal. Therapies could be developed for drug-resistant HIV infections. These remedies could be delivered intravenously to potentially clear HIV from a patient’s blood. And the venom-infused nanoparticles could be added to topical (vaginal, anal, etc) gels to prevent the initial infection during exposure.
clear HIV from a patient’s blood. And the venom-infused nanoparticles could be added to topical (vaginal, anal, etc) gels to prevent the initial infection during exposure.
But the news gets even better! Scientists believe that the bee venom could possibly be effective against other viruses—since the majority of them are minute particles that fit between the nanoparticle bumpers. Since mellitin attacks double-layered membranes (such as the viral protective envelopes) indiscriminately, other viruses could be killed in a similar fashion with this potent bee venom.
That means we may be on the verge of actually killing common as well as lethal viruses. Researchers state that the nanoparticles are easy to make and enough bee venom could be extracted to begin clinical trials in the near future.
The only limiting factor would be obtaining enough bee venom to mass-produce the therapy because bee populations are declining around the world. One study suggests that the US and UK have lost a third of their honeybee population since 2010 and that the die-off is spreading to other highly populated countries, including China and India, in a phenomenon called colony collapse disorder (CCD).
Barring a shortage of bee venom, however, the implications of this new medical  approach are that other viral infections—such as Hepatitis B and C, the common cold, flu viruses and possibly even Ebola—could be treated with venom-loaded nanoparticles in much the same way that we cure bacterial infections with antibiotics.
approach are that other viral infections—such as Hepatitis B and C, the common cold, flu viruses and possibly even Ebola—could be treated with venom-loaded nanoparticles in much the same way that we cure bacterial infections with antibiotics.
Thought? Comments? I’d love to hear them!

Hi James. Wow, your posts never cease to amaze! It’s remarkable that solutions to health problems like these often can be found right before our eyes. Thanks for all the research you put into your postings and for sharing the extraordinary results.
Thanks, Jim!
My posts the last couple of weeks sort of gave the bad side of medical technology with drug-resistant bacteria. I thought a ray of hope was in order. 🙂